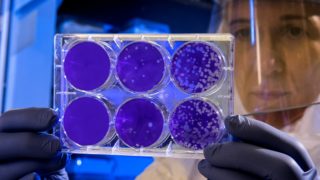

Energie je málo a bude drahá
Během několika příštích měsíců může cena energie vystoupat „…až o desítky procent“, varují odborníci.
Není to nijak překvapivé. Elektřina zdražuje trvale s tím, jak se v celé Evropě rozšiřují instalace nejlevnějších a nejefektivnějších bezemisních zdrojů a naopak se odstavují tepelné elektrárny. Tentokrát ale, podle expertů, nastal souběh různých okolností.
povolenky: výkyv nebo trend?
Tou už tradičně citovanou je růst ceny emisních povolenek. Nelze jednoznačně říci, zda je příčinou, že jich je vzhledem k množství vypouštěného oxidu uhličitého málo. Množství povolenek reguluje stát tím, kolik jich emituje. Z jejich prodeje pak dotuje v první řadě svůj rozpočet, menší část příjmů vkládá do podpory ekologických opatření. S tím, jak se omezuje provoz tepelných elektráren (a oceláren, cementáren, apod.), klesají příjmy státu z prodeje povolenek. S čím se možná nepočítalo jsou nákupy povolenek na specializovaných burzách. Tyto spekulativní obchody vyhnaly cenu povolenky na zhruba trojnásobek odhadované a energetickými podniky kalkulované ceny. Analytici tvrdí, že emisní povolenky budou dražší trvale s tím, jak se zpřísňují ekologické předpisy. Nakolik ale současné nebo i budoucí ceny odrážejí jejich skutečnou rostoucí potřebu a do jaké míry se jedná o burzovní výkyv, toť otázka otevřená.

Jestli si ovšem někdo představoval, že povolenky se budou týkat především výrobců elektřiny, že se jejich produkt stane konkurence neschopným a odjede z trhu pod tlakem levné energie z větrných a solárních elektráren, zmýlil se. Výkony elektráren na fosilní paliva jsou pro plynulé a kvalitní zásobování elektřinou stále nezbytné. Výsledek je ten, že elektřina je zdaněna nadvakrát. Jedou tzv. podporou na OZE, podruhé pokutou za vypouštění CO2. Teď jde o to, jak dlouho si to spotřebitelé budou moci dovolit. Nebo jak dlouho si to nechají líbit.
uhlí jde také nahoru
Další okolností je růst energetických potřeb Číny a Indie. Skupují uhlí a to pak podražuje. České republiky by se to nemuselo dotknout přímo, alespoň dokud těžíme a využíváme uhlí svoje, hnědé. S tím se na světových burzách prakticky neobchoduje, narozdíl od uhlí černého nebo od elektřiny. Ale jeho ceny budou časem cenami uhlí obchodovaného ovlivněny.
Do třetice je tu oživení světové ekonomiky po pandemii. To se odráží hlavně v cenách ropy a zemního plynu, jež ale opět nachází odezvu i v cenách energie obecně. Ceny ropy se patrně zklidní, ale o mnoho dolů nepůjdou, to si ohlídá kartel vývozců OPEC+.
Teď je tu otázka, jak se s vývojem cen energie mohou vypořádat spotřebitelé. V první řadě úsporami. Ty ale nemusejí být pro každého dosažitelné, nebo ne hned. Navíc i v tomto oboru dochází ke zdražování. Stavební materiál včetně izolací je těžko k mání a jeho ceny, stejně jako ceny stavebních prací, rovněž rostou. A bylo by s podivem, kdyby nestoupaly také ceny přístrojů a technologií.
regulace je komplikace
Teoreticky jsou možné zásahy státu, vždyť např. více než polovina konečné ceny elektřiny je regulována. Ovšem změnu regulačních pravidel nelze uskutečnit ze dne na den. Snad jen snížení daně z přidané hodnoty na energii je možné realizovat snadným rozhodnutím, aniž by to nějak ublížilo výrobcům. Také by bylo možné kompenzovat část nákladů výrobců spojených s nákupem emisních povolenek. V některých průmyslových oborech se tak děje, ale energetika mezi nimi není a s největší pravděpodobností by rozhodnutí leželo na Evropské komisi, ne na české vládě.
Možností, jak se bránit zdražování energie, tedy není mnoho na výběr. Asi nezbyde, než si zvyknout.